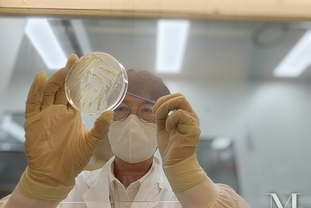

[ 경기뉴스매거진 ] 선전, 중국 2025년 5월 21일 -- 메이주(Meizu)가 MWC 2025에서 주목받는 제품을 선보이고, 지리(Geely)와의 전략적 협력을 발표한 데 이어 5월 20일 온라인 출시 행사를 통해 글로벌 시장 진출에 대한 강한 의지를 다시 한번 드러냈다. 이번 행사에서는 스마트폰 신제품 5종(MEIZU Mblu 22, Mblu 22 Pro, Note 22, Note 22 5G, Note 22 Pro 5G)과 함께 AR 스마트 글래스 StarV View, 건강관리 웨어러블 StarV Ring2가 공개됐다. 이번 출시는 '올인 AI(All in AI)' 전략과 혁신적이고 상호 연결된 생태계를 구축하려는 메이주의 비전이 반영된 것으로, 글로벌 시장 재도약의 신호탄으로 평가된다.
모바일 혁신의 새로운 정의 : 차세대 스마트폰 포트폴리오

가치 중심의 소비자를 위해 설계된 메이주 Mblu 22와 Mblu 22 Pro는 합리적인 가격과 고성능의 균형을 갖춘 제품이다. Mblu 22는 90Hz 주사율을 지원하는 6.79인치 HD+ 디스플레이와 옥타코어 프로세서를 탑재해 부드럽고 안정적인 성능을 제공한다. 5000mAh 배터리로 하루 종일 사용할 수 있으며, F1.8 대구경 카메라는 풍경부터 인물까지 선명하고 인상적인 사진을 촬영할 수 있다. 가격대는 79~89달러다.

메이주 Mblu 22 Pro는 MediaTek Helio G81 프로세서, 6.79인치 FHD+ 120Hz 울트라 스무스 디스플레이, 5000만 화소 울트라 HD 메인 카메라와 200만 화소 매크로 카메라를 탑재해 사용자 경험을 한층 끌어올렸다. 타이탄 쉴드 아키텍처는 고강도 소재로 제작됐으며, 엄격한 안정성 테스트를 거쳐 내구성을 강화했다. 가격대는 99~129달러다.

메이주 Note 22 라인업은 성능과 가격의 완벽한 조화로 기술 마니아들을 겨냥한 제품이다. 메이주 Note 22는 1억 800만 화소 메인 카메라, 800만 화소 초광각 카메라, 200만 화소 인물 카메라로 구성된 트리플 카메라 시스템을 탑재해 낮과 밤을 가리지 않고 매 순간을 생동감 있게 포착한다. 5000mAh 배터리는 40W 고속 충전을 지원하며, 6.78인치 FHD+ 120Hz 울트라 AMOLED 디스플레이는 부드러운 인터랙션을 구현한다. 가격대는 179~299달러다.

메이주 Note 22 5G는 최대 24GB 램을 탑재해 장시간 부드럽고 안정적인 사용 환경을 제공한다. 5G 네트워크를 지원하며, AI 장면 최적화 기능이 적용된 5000만 화소 트리플 카메라 시스템으로 사진 품질을 높였다. 또한 중국 전통 건축에서 영감을 받은 세련된 디자인은 제품의 프리미엄 감성을 한층 돋보이게 한다. 가격대는 169~229달러다.

메이주 Note 22 Pro 5G는 Snapdragon 7s 3세대 프로세서와 5000만 화소 울트라 HD 메인 카메라를 탑재했다. 또한 사용자의 습관을 학습해 배터리 수명, 앱 성능, 멀티태스킹을 최적화하는 메이주의 독자적인 Flyme AIOS를 지원한다. 6200mAh 대용량 배터리는 80W 고속 충전을 지원해 하루 종일 배터리 걱정 없이 사용할 수 있다. 가격대는 299~369달러다.

스마트폰을 넘어 : StarV View AR 글래스와 StarV Ring2
메이주는 이번 출시 행사에서 스마트 웨어러블 제품도 글로벌 시장에 선보였다. StarV View는 세련된 디자인에 최첨단 증강현실(AR) 기능이 결합된 제품이다. 85mm/LP 초고화질, 10단계 밝기 조절이 가능한 188인치 120Hz 디스플레이를 탑재해 사용자에게 영화관 같은 몰입형 시청 경험을 제공한다. 또한 무게가 74g에 불과해 휴대성이 뛰어나며, 0~600디옵터 시력 조절도 지원해 근시 사용자도 편하게 사용할 수 있다. StarV View는 그야말로 '주머니 속 개인 극장'이라고 불러도 손색이 없다.

StarV Ring2는 웨어러블 헬스 기술에 새로운 혁신을 불러온 제품이다. 이 링을 착용하면 수면 데이터를 추적하고 수면의 질을 평가할 수 있으며, 심박수와 운동 시간을 모니터링해 건강과 스트레스 관리를 효과적으로 도와준다. IP68 등급의 방수 기능을 갖춰 수영 중에도 안심하고 착용할 수 있으며, Flyme OS 기반으로 작동해 링 하나로 휴대전화나 스마트 글래스를 제어할 수 있다.

Flyme AI 생태계의 해외 전략
이러한 스마트폰과 웨어러블 제품은 러시아, 스페인, 말레이시아, 베트남에서 우선 출시되며, 이후 아시아 태평양, 라틴아메리카, 중동, 중앙아시아, 유럽 등 30여 개 국가와 지역에서 판매될 예정이다. 이번 신제품 출시 행사는 메이주가 '스마트폰 + XR + 스마트카' 생태계를 기반으로, 기기 간 끊김 없는 연결 경험을 제공하며 글로벌 시장에서 새로운 도약을 이뤘음을 보여준다.
메이주의 향후 로드맵을 강조한 청 리(Cheng Li) 글로벌 비즈니스 최고마케팅책임자(CMO)는 "우리의 '올인 AI' 전략은 하드웨어, 소프트웨어, 서비스를 유기적으로 연결해 끊김 없는 스마트 라이프를 구현하는 것"이라며 "앞으로도 다양한 국가와 지역의 소비자 습관에 맞춰 가성비가 뛰어나고 맞춤형 기능을 갖춘 전자제품을 지속적으로 개발해 나가겠다"고 밝혔다.
메이주는 드림스마트 그룹(DreamSmart Group)의 스마트폰 브랜드로 스마트폰•XR•스마트카 등 세 가지 제품 분야에서 AI 기술을 적용한 제품을 선보이고 있다. 드림스마트는 다양한 산업 분야에서 축적한 기술력을 바탕으로, 스마트 디바이스 생태계를 주도하는 기업으로 자리매김했다.
이번 출시는 단순한 제품 공개가 아니라 AI 중심의 미래를 선언하는 것이다. 메이주는 우수한 하드웨어와 적응형 인텔리전스를 결합해 기술이 사용자의 니즈를 앞서 예측하는 시대를 이끌고 있다. 스마트폰, AR 글래스, 헬스 웨어러블이 유기적으로 연결되며 메이주는 혁신•연결성•사용자 중심 디자인의 새로운 글로벌 기준을 제시하고 있다.